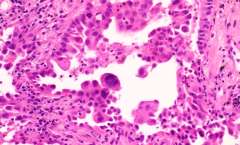
adenoCA

Pathology
Cardiopulmonary Pathology

Cardiopulmonary Pathology
Recent technological advances, including transplantation technologies as well as artificial hearts, valves and stents, have added a new layer of complexity to the study of the number one killer in America, cardiovascular disease. Likewise, pathologic analyses are crucial for the diagnosis of many intrinsic pulmonary diseases and assessment of post-lung transplant disorders. UCLA Cardiovascular and Pulmonary pathologists are expert in the diagnosis of a wide variety of cardiopulmonary and circulatory system problems, as well as complex cases involving mechanical devices. Both biopsy and autopsy consultations are performed.
Services
- Review of surgical pathology specimens (i.e., heart and lung biopsies, excised native and artificial heart valves and blood vessels
- Consultation services on complex autopsy specimens (complex congenital heart diseases; hearts with implanted mechanical devices such as ventricle assist devices, artificial valves and arterial stents).
Education
- Conferences
- Cardiopulmonary Pathology Fellowship
- Medical student teaching
- Resident training
Research
- Clinical research services
- Lung cancer
- Interstitial lung diseases
- Lung transplant pathology
- Cardiac transplantation pathology and cardiomyopathy



